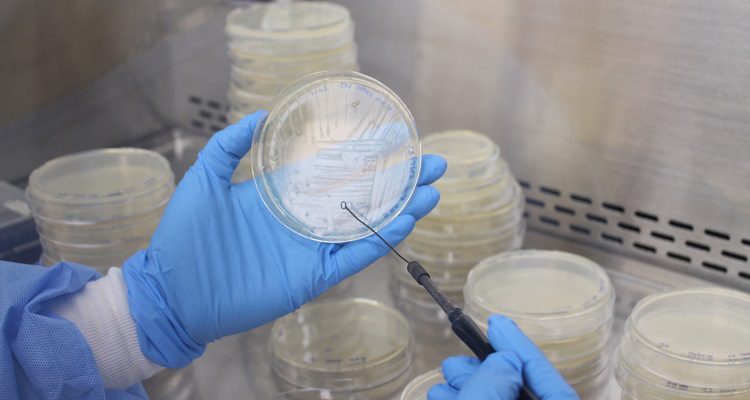

A través de los Policy Brief, INCAR pretende informar a la sociedad y promover cambios e innovación en las políticas públicas.
 Piscirickettsia salmonis es una bacteria intracelular facultativa y es reconocida como el agente causante de la Piscirickettsiosis o SRS, causando pérdidas económicas a la salmonicultura cercanas a los 700 millones de dólares, requiriendo el uso de importantes cantidades de antibióticos en diferentes etapas del ciclo productivo. Actualmente, el análisis genético y signos clínicos de la enfermedad nos han permitido identificar dos grupos genéticos principales de P. salmonis (LF-89 y EM-90), los cuales están asociados con brotes de la enfermedad en los centros de cultivo de salmónidos.
Piscirickettsia salmonis es una bacteria intracelular facultativa y es reconocida como el agente causante de la Piscirickettsiosis o SRS, causando pérdidas económicas a la salmonicultura cercanas a los 700 millones de dólares, requiriendo el uso de importantes cantidades de antibióticos en diferentes etapas del ciclo productivo. Actualmente, el análisis genético y signos clínicos de la enfermedad nos han permitido identificar dos grupos genéticos principales de P. salmonis (LF-89 y EM-90), los cuales están asociados con brotes de la enfermedad en los centros de cultivo de salmónidos.
El centro INCAR ha realizado esfuerzos significativos para generar conocimiento científico de excelencia, útil para la formulación de políticas públicas y el diseño de herramientas para la vigilancia epidemiológica de P. salmonis y el desarrollo de nuevos productos para la prevención de la enfermedad.
En este sentido, un grupo de investigadores de las líneas “Salud Animal en Ambiente Marino” y “Salud animal en estadios de vida temprana de salmónidos y recursos nativos” del centro, integrado por Adolfo Isla, Dr. Rubén Avendaño-Herrera, Dr. Jaime Figueroa y Dr. Alejandro Yáñez, preparó un nuevo Policy Brief, titulado “Innovaciones en la genotipificación de la Piscirickettsiosis para un enfoque integrado de su gestión en salmonicultura”
Los investigadores del centro liderados por el grupo del Dr. Yáñez han sido pioneros en el desarrollo de los primeros medios de cultivo líquido y en placa libres de sangre, lo que ha facilitado el desarrollo de vacunas, metodología de MICs y el aislamiento de cepas puras.
Esto ha permitido aislar el ADN de cepas aisladas de colonia única y obtener información genómica mediante la secuenciación de 80 aislados chilenos de P. salmonis, confirmando la existencia de los dos distintos genogrupos LF-89 y EM-90 y su asociación con variaciones en la virulencia. Esta información ha posibilitado proponer inicialmente un esquema de Multilocus Sequence Typing (MLST), único para P. salmonis y considerado un estándar de oro para el seguimiento epidemiológico de los aislados causantes de la Piscirickettsiosis, mediante la secuenciación de 7 genes de cada cepa. Recientemente, se ha divulgado una técnica de identificación y genotipificación basada en la Reacción en Cadena de la Polimerasa Múltiple o PCR-multiplex, que proporciona información rápida y precisa sobre la presencia de cada genogrupo en los centros de cultivo.
Dada la importancia de clasificar la mortalidad según la causa, como en el caso de la Piscirickettsiosis, y de diagnosticar a su agente mediante diversas metodologías disponibles en los laboratorios de diagnóstico de la red del Servicio Nacional de Pesca y Acuicultura, es esencial también reconocer y asignar el genotipo asociado al cuadro infeccioso en salmónidos en el centro de cultivo. Esta información permitirá comprender mejor el potencial patogénico y generar conocimiento para el desarrollo u optimización de métodos de prevención. En este contexto, la presente propuesta tiene como objetivo implementar una plataforma genética que permita identificar a P. salmonis y discriminar entre los genogrupos LF-89 y EM-90. La implementación masiva de estas metodologías permitirá una diagnosticar con precisión la causa de mortalidad e identificar los genogrupos específicos durante brotes de la patología, contribuyendo a una mejor comprensión de la epidemiología de la enfermedad y facilitando la toma de decisiones para la prevención y control de los brotes. Además, estas técnicas genómicas pueden ser cruciales para identificar la fuente de la infección y las posibles rutas de transmisión. lo que ayuda a personalizar los tratamientos, identificar la propagación de la enfermedad y desarrollar vacunas efectivas, llevando en última instancia a una mejor gestión de Piscirickettsiosis y tener poblaciones de peces más saludables.
A través de las “Recomendaciones desde la ciencia para políticas públicas” o “Policy Briefs”, INCAR pretende informar a la sociedad y promover cambios e innovación en las políticas públicas, basados en la mejor ciencia, para abordar problemas estratégicos del sector bajo el marco del enfoque ecosistémico a la acuicultura.
Revisa y descarga el documento completo aquí.




